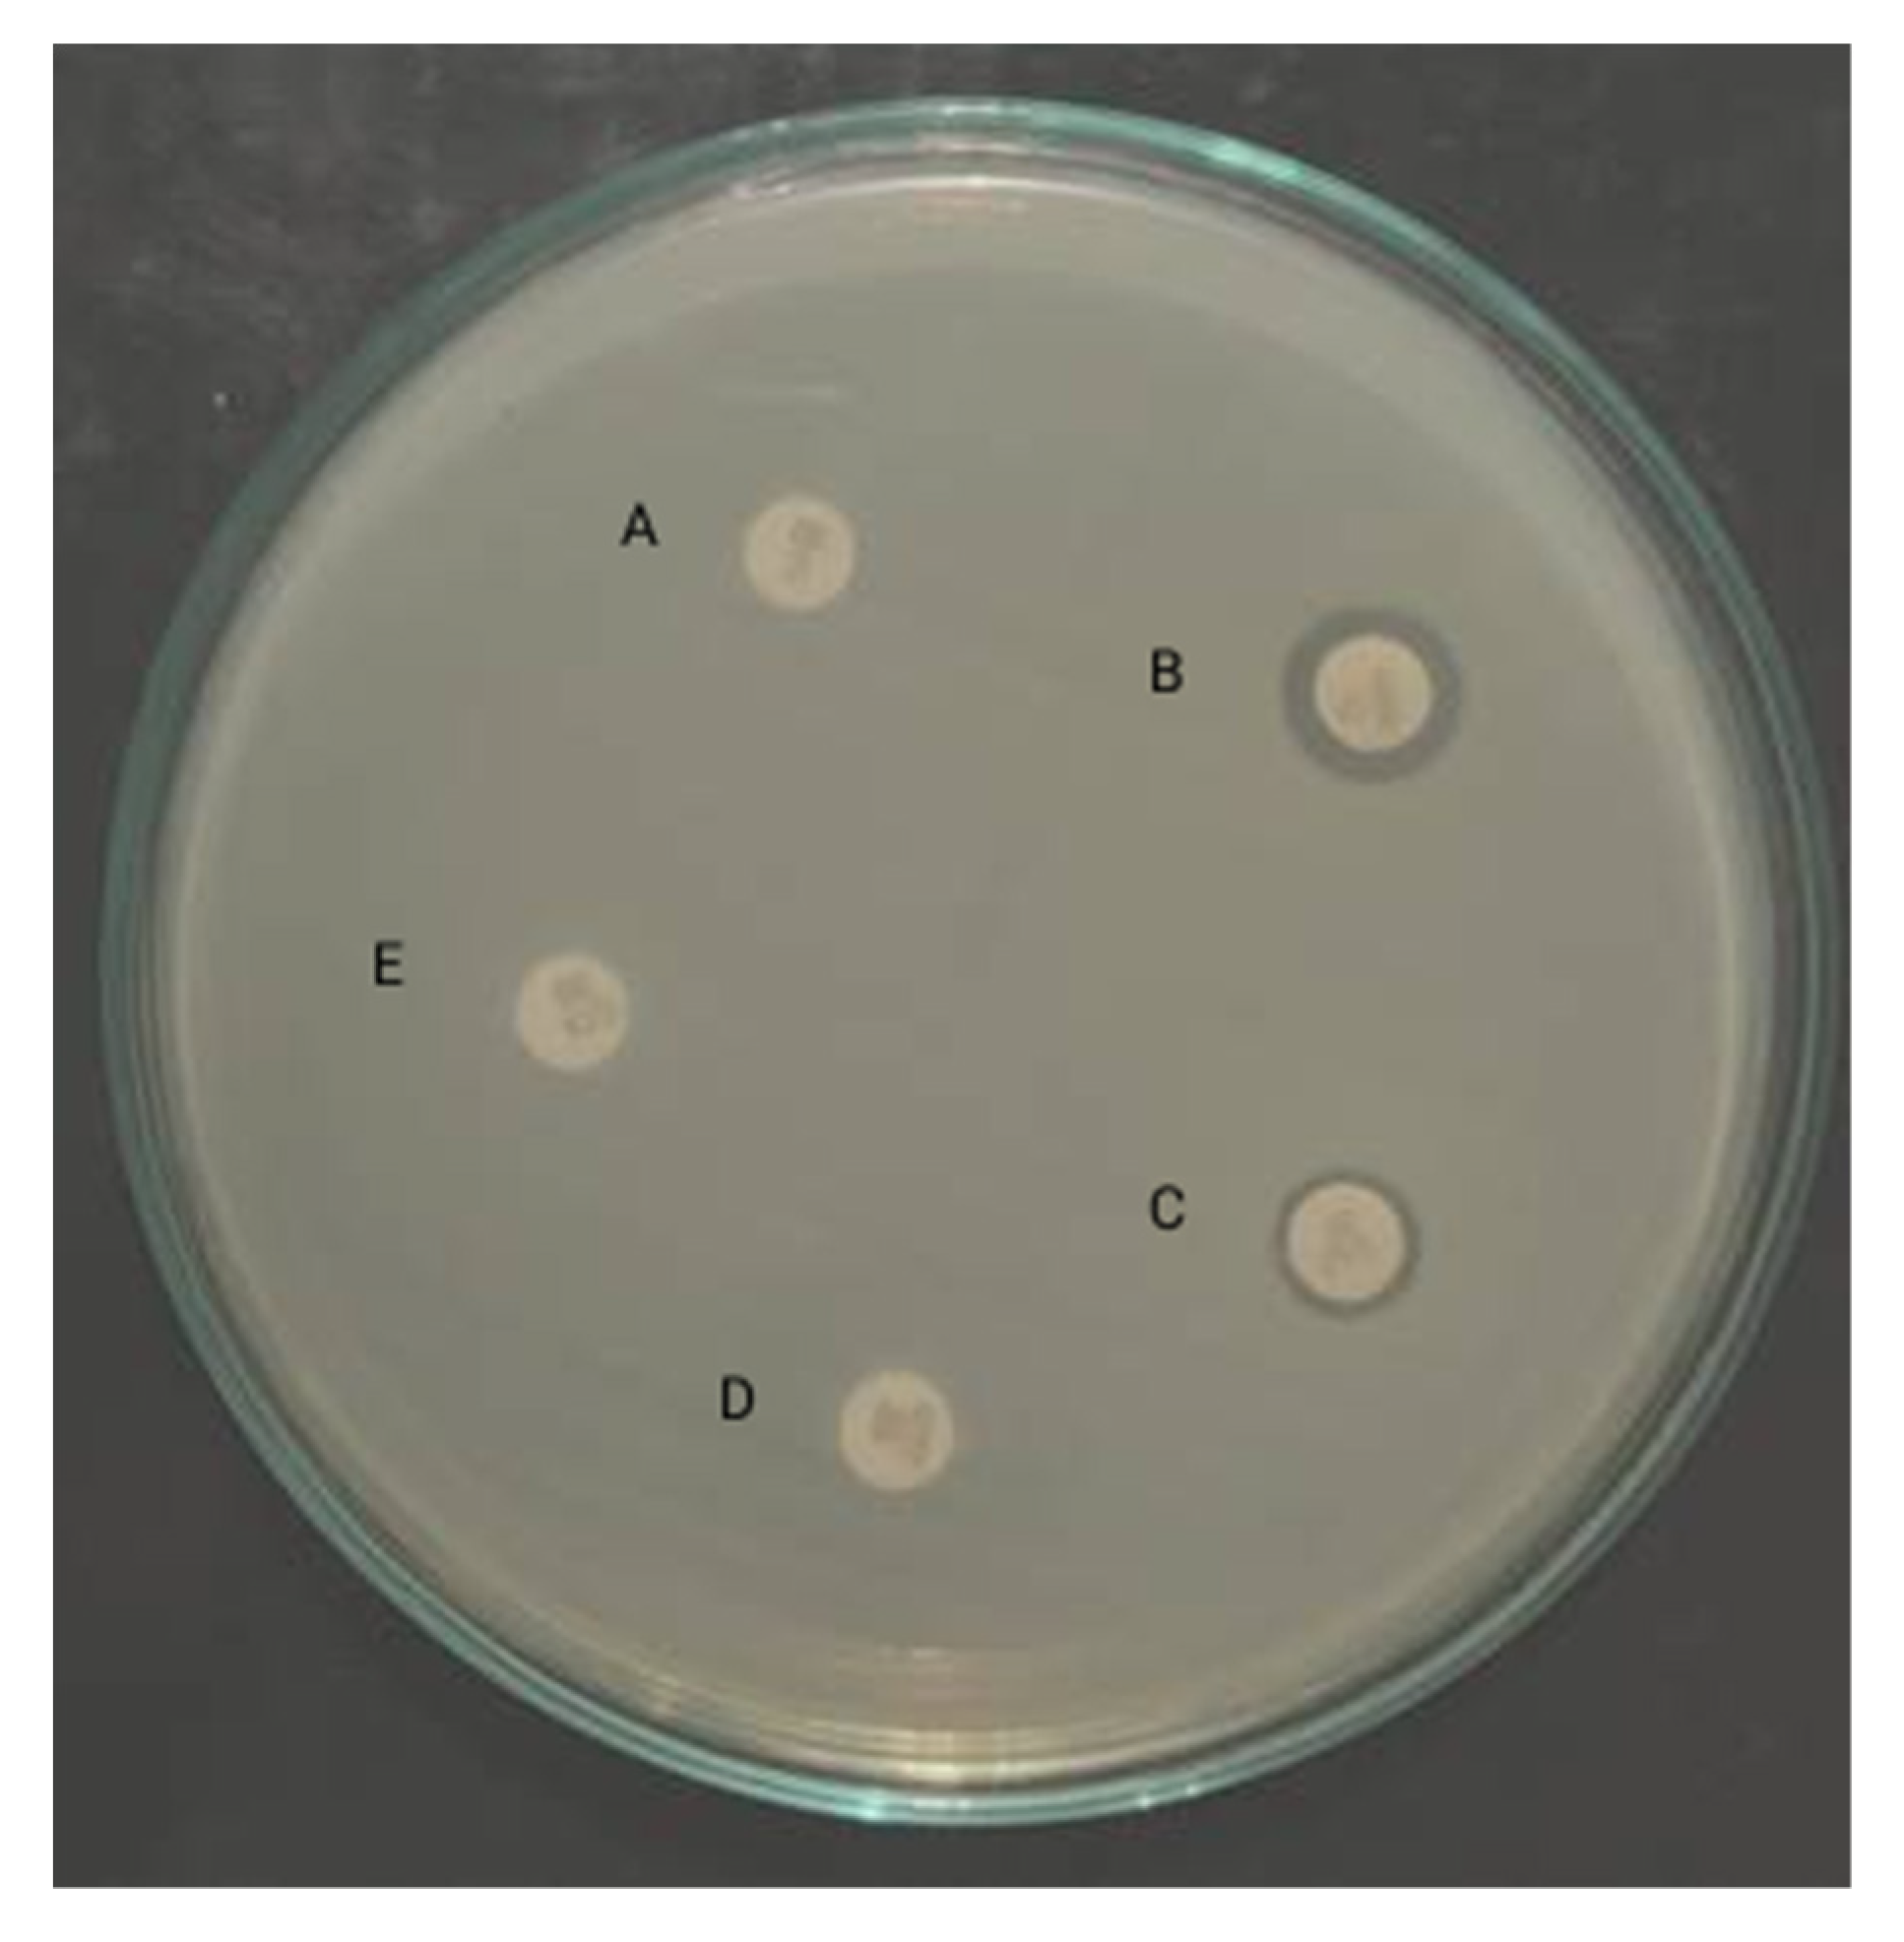
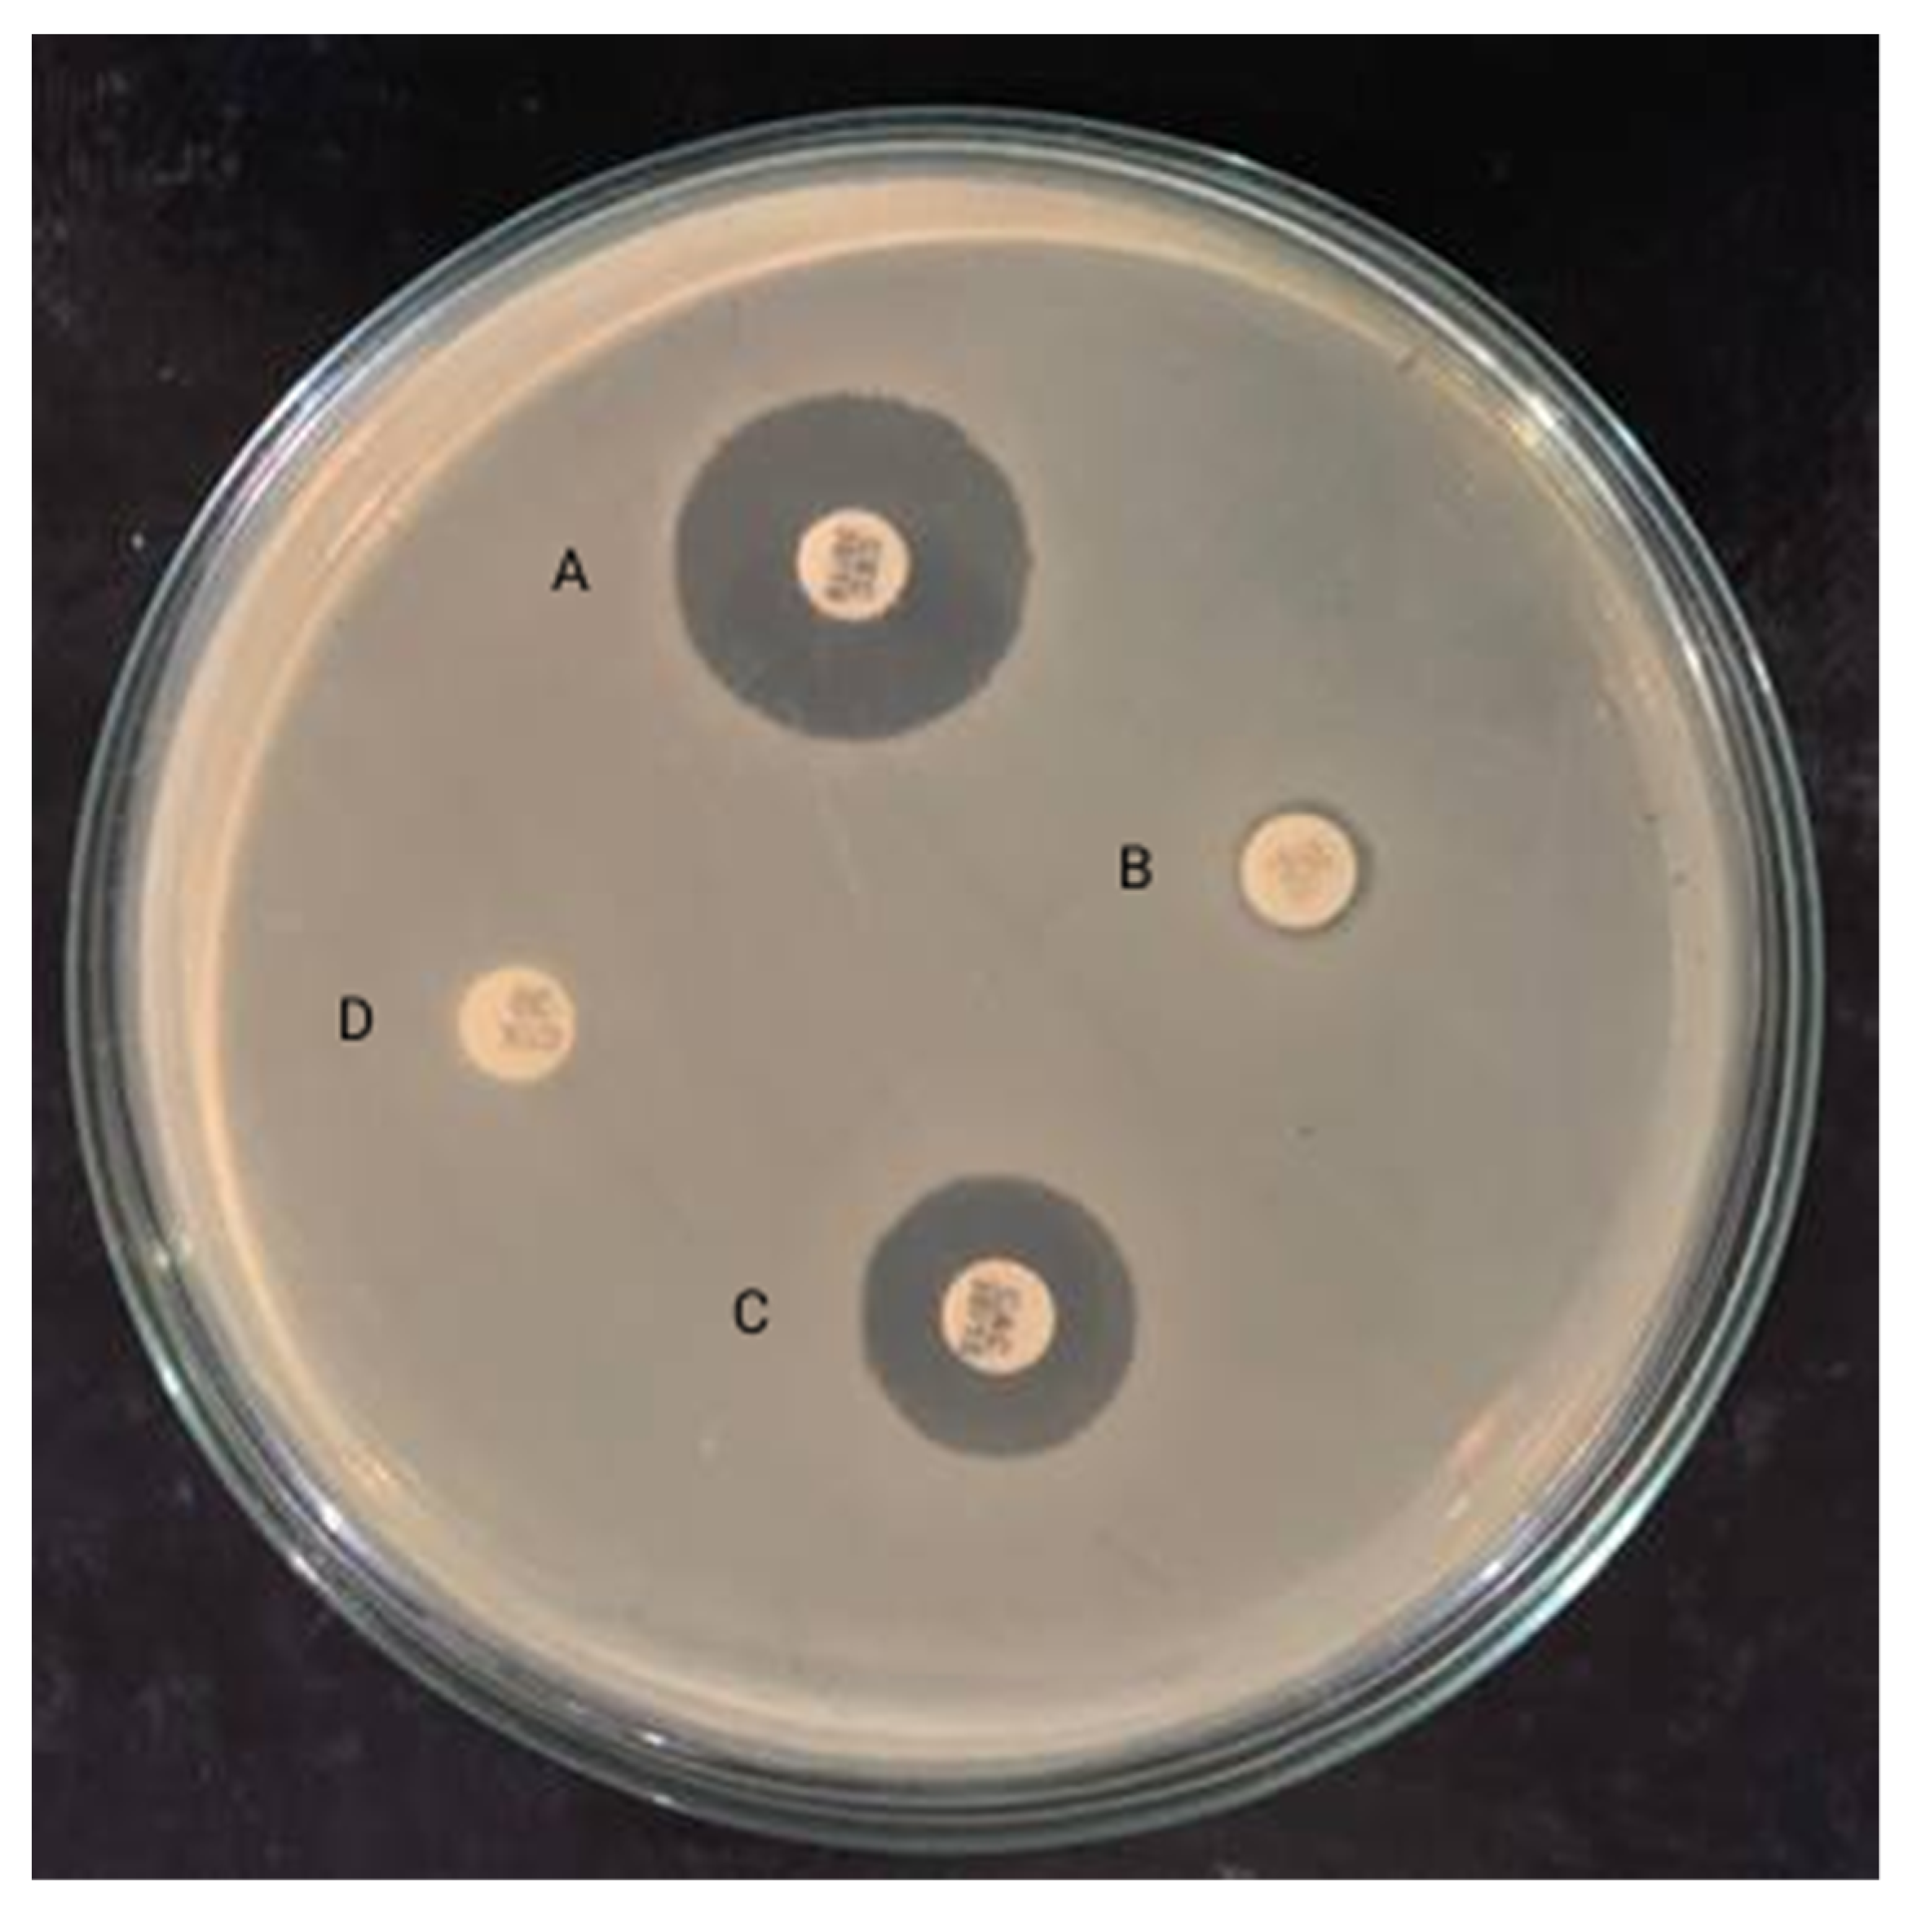

Microbial and Parasitic Contamination of Fresh Raw Vegetable Samples and Detection of the BlaTEM and BlaCTX-M Genes from E. coli Isolates
Abstract
1. Introduction
2. Methodology
2.1. Parasitological Analysis of Vegetable
- Simple smear: A drop of sediment was applied on the center of a clean grease-free slide. A clean cover slip was placed gently to avoid air bubbles and overflooding. The preparation was examined under a light microscope using 10× and 40× objectives.
- Iodine smear: A drop of sediment was mixed with a drop of lugol′s iodine solution and examined in the same way as the simple smear.
2.2. Total Coliform Count
- Presumptive testThree single strength lactose broth tubes were labeled as ″0.1″, another 3 tubes ″1″ and 3 double strength broth tubes ″10″. Each ″10″ tube was aseptically inoculated with 10 mL of sample, the ″1″ tubes were aseptically inoculated with 1 mL of sample using a 1 mL sterile pipette and the ″0.1″ tubes were inoculated aseptically with 0.1 mL of sample using a sterile pipette. All of the nine-inoculated tubes were incubated at 37 °C for 24–48 h.
- Confirmed testAll primary tubes showing any amount of gas or acid within 24–48 h of incubation were submitted to the confirmed phase. Primary tubes (positive) were gently shaken to re-suspend the organism. The EMB agar plate was inoculated with the positive culture with a sterile inoculating loop. The plate was incubated for 24–48 h at 37 °C in the inverted position.
- Completed testTo establish definitely the presence of coliform bacteria and to provide quality control data, the completed test was used on all positive confirmed cases. The lactose-fermentation broth tube was inoculated with the isolated colony from an agar plate using an inoculated loop. The nutrient agar was streaked with the colony from an agar plate with an inoculated loop. The organism on the nutrient agar was tested for gram stain, and subjected to biochemical tests, and identified as coliform [21].
2.3. Antimicrobial Susceptibility Testing
2.4. Phenotypic Characterization of the ESBL Producers
2.5. Molecular Characterization of BlaTEM and BlaCTX-M Genes
2.6. Data Analysis
3. Results
3.1. Distribution of Intestinal Parasitic Contamination
3.2. Parasitic Contamination in Vegetable Sample
3.3. Distribution of Parasites According to Districts in Vegetable Sample
3.4. Multiple Parasites Contamination in Vegetables
3.5. Coliform Bacteria in Fresh Vegetables, Five Type of Sample
3.6. Antibiotic Susceptibility Pattern of E. coli
3.7. ESBL-Producing MDR E. coli
3.8. Detection of ESBL Genes
4. Discussion
5. Conclusions and Recommendations
5.1. Conclusion
5.2. Recommendations
Author Contributions
Funding
Acknowledgments
Conflicts of Interest
References
- Amoah, P.; Drechsel, P.; Abaidoo, R.C.; Klutse, A. Effectiveness of common and improved sanitary washing methods in selected cities of West Africa for the reduction of coliform bacteria and helminth eggs on vegetables. Trop. Med. Int. Health 2007, 12, 40–50. [Google Scholar] [CrossRef] [PubMed]
- Hamilton-Miller, J.M. Identity and antibiotic susceptibility of enterobacterial flora of salad vegetables. Int. J. Antimicrob. Agents 2001, 18, 81–83. [Google Scholar] [CrossRef]
- Holvoet, K.; Sampers, I.; Callens, B.; Dewulf, J. Moderate Prevalence of antimicrobial resistance in Escherichia coli isolates from lettuce, irrigation water, and soil. Appl. Environ. Microbiol. 2013, 79, 6677–6683. [Google Scholar] [CrossRef] [PubMed]
- Beuchat, L.R. Pathogenic microorganisms associated with fresh produce. J. Food Prot. 1996, 59, 204–216. [Google Scholar] [CrossRef] [PubMed]
- Bekele, F.; Tefera, T.; Biresaw, G.; Yohannes, T. Parasitic contamination of raw vegetables and fruits collected from selected local markets in Arba Minch town, Southern Ethiopia. Infect. Dis. Poverty 2017, 6, 1–7. [Google Scholar] [CrossRef]
- Alhabbal, A.T. The prevalence of parasitic contamination on common sold vegetables in alqalamoun region. Int. J. Pharm. Sci. Rev. Res. 2016, 30, 94–97. [Google Scholar]
- Olyaei, A.; Hajivandi, L. Parasitological contamination of markets and farms in vegetables consumed in Southern Iran. Glob. Vet. 2013, 10, 327–331. [Google Scholar]
- Orok, A.; Ajibaye, O.; Babasola, A.J.; Cheng, P. IPIs in archetypal African urban slum in Nigeria. J. Microbiol. Immunol. Infect. 2016, 52, 106–113. [Google Scholar]
- Yusof, A.M.; Mohammad, M.; Abdullahi, M.A.; Mohamed, Z.; Zakaria, R. Occurrence of intestinal parasitic contamination in select consumed local raw vegetables and fruits in Kuantan, Pahang. Trop. Life Sci. Res. 2017, 28, 23–32. [Google Scholar] [CrossRef]
- Aarestrup, F.M.; Wegener, H.C.; Collignon, P. Resistance in bacteria of the food chain: Epidemiology and control strategies. Expert Rev. Anti-Infect. Ther. 2008, 6, 733–750. [Google Scholar] [CrossRef]
- Van Den Bogaard, A.E.; Stobberingh, E.E. Antibiotic usage in animals impact on bacterial resistance and public health. Drugs 1999, 58, 589–607. [Google Scholar] [CrossRef] [PubMed]
- Wooldridge, M. Evidence for the circulation of antimicrobial-resistant strains and genes in nature and especially between humans and animals and transmission of antibiotic. Rev. Sci. Tech. 2012, 31, 231–247. [Google Scholar] [CrossRef]
- Cantón, R.; González-Alba, J.M.; Galán, J.C. CTX-M enzymes: Origin and diffusion. Front. Microbiol. 2012, 3, 110. [Google Scholar] [CrossRef]
- Naseer, U.; Sundsfjord, A. The CTX-M conundrum: Dissemination of plasmids and Escherichia coli clones. Microb. Drug Resist. 2011, 17, 83–97. [Google Scholar] [CrossRef]
- Michael, G.B.; Freitag, C.; Wendlandt, S.; Eidam, C.; Feßler, A.T.; Lopes, G.V.; Kadlec, K.; Schwarz, S. Emerging issues in antimicrobial resistance of bacteria from food-producing animals. Future Microbiol. 2015, 10, 427–443. [Google Scholar] [CrossRef] [PubMed]
- Egea, P.; Navarro, M.D.; Pascual, A. Assessment of the presence of extended-spectrum beta-lactamase-producing Escherichia coli in eggshells and ready-to-eat products. Eur. J. Clin. Microbiol. Inf. Dis. 2011, 30, 1045–1047. [Google Scholar] [CrossRef] [PubMed]
- Kim, H.; Chon, J.; Kim, Y.; Kim, D.; Kim, M.; Seo, K. International Journal of Food Microbiology Prevalence and characterization of extended-spectrum-β-lactamase-producing Escherichia coli and Klebsiella pneumoniae in ready-to-eat vegetables. Int. J. Food Microbiol. 2015, 207, 83–86. [Google Scholar] [CrossRef] [PubMed]
- Bailenger, J. Mechanisms of parasiticals concentra-tion in coprology and their practical consequences. J. Am. Med. Technol. 1979, 41, 65–71. [Google Scholar]
- Fotedar, R.; Stark, D.; Beebe, N.; Marriott, D.; Ellis, J.; Harkness, J. Laboratory diagnostic techniques for Entamoeba species. Clin. Microbiol. Rev. 2007, 20, 511–532. [Google Scholar] [CrossRef]
- Rompré, A.; Servais, P.; Baudart, J.; de-Roubin, M.R.; Laurent, P. Detection and enumeration of coliforms in drinking water: Current methods and emerging approaches. J. Microbiol. Methods. 2002, 49, 31–54. [Google Scholar] [CrossRef]
- Falomir, M.P.; Gozalbo, D.; Rico, H. Coliform bacteria in fresh vegetables: From cultivated lands to consumers. Curr. Res. Technol. Educ. Top. Appl. Microbiol. Microb. Biotechnol. 2010, 2, 1175–1181. [Google Scholar]
- Thapa, P.; Parajuli, K.; Poudel, A.; Thapa, A.; Manandhar, B.; Laudari, D.; Malla, H.; Katiwada, R. Causative agents and susceptibility of antimicrobials among suspected females with urinary tract infection in tertiary care hospitals of Western Nepal. J. Chitwan. Med. Coll. 2013, 3, 16–19. [Google Scholar] [CrossRef]
- Eraky, M.A.; Rashed, S.M.; Nasr, M.E.S.; El-Hamshary, A.M.S.; Salah El-Ghannam, A. Parasitic contamination of commonly consumed fresh leafy vegetables in Benha, Egypt. J. Parasitol. Res. 2014, 2014, 613960. [Google Scholar] [CrossRef] [PubMed]
- Gupta, N.; Khan, D.K.; Santra, S.C. Prevalence of intestinal helminth eggs on vegetables grown in wastewater-irrigated areas of Titagarh, West Bengal, India. Food Control 2009, 20, 942–945. [Google Scholar] [CrossRef]
- Amahmid, O.; Asmama, S.; Bouhoum, K. The effect of waste water reuse in irrigation on the contamination level of food crops by Giardia Giardia cysts and Ascaris Ascaris eggs. Int. J. Food Microbiol. 1999, 49, 19–26. [Google Scholar] [CrossRef]
- Silva, S.; Maldonade, I.R.; Ginani, V.C.; Lima, S.A.; Mendes, V.S.; Lidiane, M.; Azevedo, X. Short Communication Detection of intestinal parasites on field-grown strawberries in the Federal District of Brazil. J. Braz. Soc. Trop. Med. 2014, 47, 801–805. [Google Scholar] [CrossRef][Green Version]
- Brooker, S.; Bethony, J.; Hotez, P.J. Human hookworm infection in the 21st century. Adv Parasitol. 2004, 58, 197–288. [Google Scholar]
- Amoah, P.; Drechsel, P.; Abaidoo, R.C.; Ntow, W.J. Pesticide and pathogen contamination of vegetables in Ghana’s urban markets. Arch. Environ. Contam. Toxicol. 2006, 50, 1–6. [Google Scholar] [CrossRef]
- Avcioglu, H.; Soykan, E.; Tarakci, U. Control of Helminth contamination of raw vegetables by washing. Vector Borne Zoonotic Dis. 2011, 11, 189–191. [Google Scholar] [CrossRef]
- Tefera, T.; Biruksew, A.; Mekonnen, Z.; Eshetu, T. Parasitic contamination of fruits and vegetables collected from selected local markets of Jimma Town, Southwest Ethiopia. Int. Sch. Res. Not. 2014, 2014, 1–7. [Google Scholar] [CrossRef]
- Valentin-bon, I.; Jacobson, A.; Monday, S.R.; Feng, P.C.H. Microbiological quality of bagged cut spinach and lettuce mixes. Appl. Environ. Microbiol. 2008, 74, 1240–1242. [Google Scholar] [CrossRef] [PubMed]
- Oliver, D.M.; van Niekerk, M.; Kay, D.; Heathwaite, A.L.; Porter, J.; Fleming, L.E.; Kinzelman, J.L.; Connolly, E.; Cummins, A.; McPhail, C.; et al. Opportunities and limitations of molecular methods for quantifying microbial compliance parameters in EU bathing waters. Environ. Int. 2014, 64, 124–128. [Google Scholar] [CrossRef] [PubMed]
- Pensala, O.; Heleniusc, H.; Huovinen, P.; Osterblad, M.; Peterzéns, M. Antimicrobial susceptibility of Enterobacteriaceae isolated from vegetables. J. Antimicrob. Chemother. 1999, 43, 503–509. [Google Scholar]
- Davies, J.; Davies, D. Origins and Evolution of Antibiotic Resistance. Microbiol. Mol. Biol. Rev. 2010, 74, 417–433. [Google Scholar] [CrossRef] [PubMed]
- Rasheed, M.U.; Thajuddin, N.; Ahamed, P.; Teklemariam, Z.; Jamil, K. Resistência microbiana a drogas em linhagens de Escherichia coli isoladas de fontes alimentares. Rev. Inst. Med. Trop. Sao Paulo 2014, 56, 341–346. [Google Scholar] [CrossRef]
- Mesa, R.J.; Blanc, V.; Blanch, A.R.; Cortés, P.; González, J.J.; Lavilla, S.; Miró, E.; Muniesa, M.; Saco, M.; Tórtola, M.T.; et al. Extended-spectrum β-lactamase-producing Enterobacteriaceae in different environments (humans, food, animal farms, and sewage). J. Antimicrob. Chemother. 2006, 58, 211–215. [Google Scholar] [CrossRef]
- Zurfluh, K.; Nüesch-Inderbinen, M.; Morach, M.; Hächler, H.; Stephan, R. Extended-Spectrum-B-Lactamase-Producing Enterobacteriaceae Isolated from Vegetables Imported from the Dominican Republic, India, Thailand, and Vietnam. Appl. Environ. Microbiol. 2015, 81, 3115–3120. [Google Scholar] [CrossRef]
- Reuland, E.A.; al Naiemi, N.; Raadsen, S.A.; Savelkoul, P.H.M.; Kluytmans, J.A.J.W.; Vandenbroucke-Grauls, C.M.J.E. Prevalence of ESBL-producing Enterobacteriaceae in raw vegetables. Eur. J. Clin. Microbiol. Infect. Dis. 2014, 33, 1843–1846. [Google Scholar] [CrossRef]
- Heuer, H.; Schmitt, H.; Smalla, K. Antibiotic resistance gene spread due to manure application on agricultural fields. Curr. Opin. Microbiol. 2011, 14, 236–243. [Google Scholar] [CrossRef]
- Knapp, E.T. Evidence of Increasing Antibiotic Resistance Gene Abundances in Archived Soils since 1940. Environ. Sci. Technol. 2010, 44, 580–587. [Google Scholar] [CrossRef]
- Hoogenboom, L.A.P.; Bokhorst, J.G.; Northolt, M.D.; van de Vijver, L.P.L. Contaminants and microorganisms in Dutch organic food products: A comparison with conventional products. Food Addit. Contam. Part A 2008, 25, 1195–1207. [Google Scholar] [CrossRef] [PubMed]
- Aryal, S.; Baniya, M.K.; Danekhu, K.; Kunwar, P.; Gurung, R.; Koirala, N. Total phenolic content, flavonoid content and antioxidant potential of wild vegetables from Western Nepal. Plants 2019, 8, 96. [Google Scholar] [CrossRef] [PubMed]
- Koirala, N.; Dhakal, C.; Munankarmi, N.N.; Ali, S.W.; Hameed, A.; Martins, N.; Sharifi-Rad, J.; Imran, M.; Arif, A.M.; Hanif, M.S.; et al. Vitex negundo Linn.: Phytochemical composition, Nutritional Analysis, and Antioxidant and Antimicrobial Activity. Cell Mol. Biol. 2020, 66, 1–7. [Google Scholar] [CrossRef] [PubMed]
- Panthi, M.; Subba, R.K.; Raut, B.; Khanal, D.P.; Koirala, N. Bioactivity evaluations of leaf extract fractions from young barley grass and correlation with their phytochemical profiles. BMC Complement. Med. Ther. 2020, 20, 64. [Google Scholar] [CrossRef] [PubMed]
- Schwaiger, K.; Helmke, K.; Hölzel, C.S.; Bauer, J. Antibiotic resistance in bacteria isolated from vegetables with regards to the marketing stage (farm vs. supermarket ). Int. J. Food Microbiol. 2011, 148, 191–196. [Google Scholar] [CrossRef] [PubMed]
- Upadhyaya, J.; Raut, J.K.; Koirala, N. Analysis of nutritional and nutraceutical properties of wild-grown mushrooms of Nepal. EC Microbiol. 2017, 12, 136–145. [Google Scholar]

| Sample | MPN | Bacterial Species | |||
|---|---|---|---|---|---|
| Cabbage (n:20) | >2400 (14/20) | Citrobacter (9/20) | E. coli (7/20) | Klebsiella spp. (9/20) | |
| 1100 (4/20) | Citrobacter (1/20) | E. coli (3/20) | Klebsiella spp. (2/20) | ||
| 210 (1/20) | Citrobacter (1/20) | Klebsiella spp. (1/20) | |||
| 53 (1/20) | E. coli (1/20) | Klebsiella spp. (1/20) | |||
| Carrot (n:20) | >2400 (10/20) | Citrobacter (6/20) | E. coli (6/20) | Klebsiella spp. (10/20) | |
| 1100 (5/20) | Citrobacter (1/20) | E. coli (2/20) | Klebsiella spp. (3/20) | ||
| 460 (1/20) | Citrobacter (1/20) | ||||
| 290 (1/20) | Citrobacter (1/20) | Klebsiella spp. (1/20) | |||
| 210 (1/20) | Klebsiella spp. (1/20) | ||||
| 150 (1/20) | Citrobacter (1/20) | Klebsiella spp. (1/20) | |||
| 43 (1/20) | E. coli (1/20) | Klebsiella spp. (1/20) | |||
| Cori-ander (n:20) | >2400 (11/20) | Citrobacter (7/20) | E. coli (4/20) | Klebsiella spp. (8/20) | E. cloacae (1/20) |
| 1100 (6/20) | Citrobacter (1/20) | E. coli (4/20) | Klebsiella spp. (5/20) | ||
| 93 (1/20) | E. coli (1/20) | Klebsiella spp. (1/20) | |||
| 15 (1/20) | E. coli (1/20) | Klebsiella spp. (1/20) | |||
| 6 (1/20) | Klebsiella spp. (1/20) | ||||
| Capcicum (n:20) | >2400 (13/20) | Citrobacter (6/20) | E. coli (7/20) | Klebsiella spp. (9/20) | E. cloacae (2/20) |
| 1100 (3/20) | E. coli (2/20) | Klebsiella spp. (2/20) | |||
| 460 (1/20) | E. coli ((1/20) | ||||
| 240 (2/20) | E. coli (2/20) | Klebsiella spp. (1/20) | |||
| 210 (1/20) | Citrobacter (1/20) | E. coli ((1/20) | |||
| Lettuce (n:20) | >2400 (16/20) | Citrobacter (5/20) | E. coli (10/20) | Klebsiella spp. (14/20) | E. cloacae (1/20) |
| 1100 (1/20) | E. coli (1/20) | ||||
| 460 (1/20) | E. coli (1/20) | Klebsiella spp. (1/20) | |||
| 29 (1/20) | Citrobacter (1/20) | E. coli (1/20) | Klebsiella spp. (1/20) | ||
| 28 (1/20) | E. coli (1/20) | Klebsiella spp. (1/20) | |||
| Total E. coli Isolates (%) | No. of MDR Strains (%) | No. of Suspected ESBL Producers (%) | No. of Confirmed ESBL Producers (%) |
|---|---|---|---|
| 57 | 33 | 10 | 4 |
| ESBL Genotypes | TEM | CTX-M |
|---|---|---|
| Positive | 2 | 2 |
| Negative | 2 | 2 |
| Total | 4 | 4 |
© 2020 by the authors. Licensee MDPI, Basel, Switzerland. This article is an open access article distributed under the terms and conditions of the Creative Commons Attribution (CC BY) license (http://creativecommons.org/licenses/by/4.0/).
Share and Cite
Ghimire, A.; Upadhyaya, J.; Nayaju, T.; Lekhak, B.; Chaudhary, D.K.; Raghavan, V.; Pant, B.R.; Bajgai, T.R.; Koirala, N.; Upreti, M.K. Microbial and Parasitic Contamination of Fresh Raw Vegetable Samples and Detection of the BlaTEM and BlaCTX-M Genes from E. coli Isolates. Agriculture 2020, 10, 341. https://doi.org/10.3390/agriculture10080341
Ghimire A, Upadhyaya J, Nayaju T, Lekhak B, Chaudhary DK, Raghavan V, Pant BR, Bajgai TR, Koirala N, Upreti MK. Microbial and Parasitic Contamination of Fresh Raw Vegetable Samples and Detection of the BlaTEM and BlaCTX-M Genes from E. coli Isolates. Agriculture. 2020; 10(8):341. https://doi.org/10.3390/agriculture10080341
Chicago/Turabian StyleGhimire, Alina, Jitendra Upadhyaya, Tulsi Nayaju, Binod Lekhak, Dhiraj Kumar Chaudhary, Vijaya Raghavan, Bhoj Raj Pant, Tirtha Raj Bajgai, Niranjan Koirala, and Milan Kumar Upreti. 2020. "Microbial and Parasitic Contamination of Fresh Raw Vegetable Samples and Detection of the BlaTEM and BlaCTX-M Genes from E. coli Isolates" Agriculture 10, no. 8: 341. https://doi.org/10.3390/agriculture10080341
APA StyleGhimire, A., Upadhyaya, J., Nayaju, T., Lekhak, B., Chaudhary, D. K., Raghavan, V., Pant, B. R., Bajgai, T. R., Koirala, N., & Upreti, M. K. (2020). Microbial and Parasitic Contamination of Fresh Raw Vegetable Samples and Detection of the BlaTEM and BlaCTX-M Genes from E. coli Isolates. Agriculture, 10(8), 341. https://doi.org/10.3390/agriculture10080341

